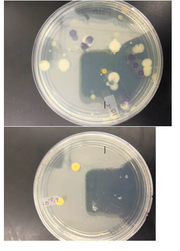
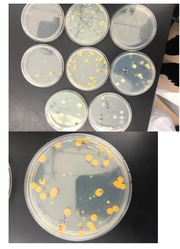
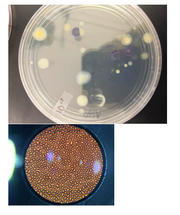
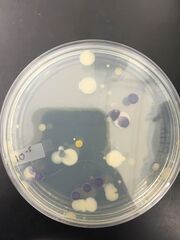
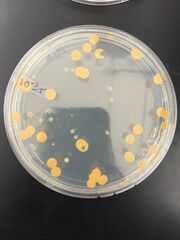

Uploads by Paola Quinones Lopez
From OpenWetWare
Jump to navigationJump to search
This special page shows all uploaded files.
| Date | Name | Thumbnail | Size | Description |
|---|---|---|---|---|
| 16:39, 18 March 2016 | Screen Shot 2016-03-17 at 4.28.23 PM.png (file) |  |
85 KB | |
| 00:21, 2 March 2016 | Dpq20153.png (file) |  |
26 KB | |
| 00:21, 2 March 2016 | Dpq20152.png (file) |  |
36 KB | |
| 00:21, 2 March 2016 | Pq20154.JPG (file) |  |
1.92 MB | |
| 00:21, 2 March 2016 | Dpq20151.png (file) |  |
41 KB | |
| 00:21, 2 March 2016 | Pq20153.JPG (file) |  |
1.51 MB | |
| 00:21, 2 March 2016 | Pq20152.JPG (file) |  |
1.52 MB | |
| 00:21, 2 March 2016 | Pq20151.JPG (file) |  |
1.37 MB | |
| 03:02, 26 February 2016 | Lab5.JPG (file) |  |
1.19 MB | |
| 03:02, 26 February 2016 | Lab5-3.jpg (file) |  |
858 KB | |
| 03:02, 26 February 2016 | Lab5-2.jpg (file) |  |
739 KB | |
| 03:02, 26 February 2016 | Lab5-1.jpg (file) |  |
1.29 MB | |
| 03:02, 26 February 2016 | Lab5-4.png (file) |  |
34 KB | |
| 23:45, 11 February 2016 | 4-5.png (file) |  |
207 KB | |
| 23:45, 11 February 2016 | 4-4.png (file) |  |
232 KB | |
| 23:45, 11 February 2016 | 4-3.png (file) |  |
266 KB | |
| 23:45, 11 February 2016 | 4-2.png (file) |  |
509 KB | |
| 23:45, 11 February 2016 | 4-1.png (file) |  |
88 KB | |
| 23:43, 11 February 2016 | 4-6.png (file) |  |
161 KB | |
| 01:48, 5 February 2016 | Pq2015-6.png (file) | |
257 KB | |
| 01:48, 5 February 2016 | Pq2015-5.png (file) | |
302 KB | |
| 01:48, 5 February 2016 | Pq2015-4.png (file) | |
239 KB | |
| 01:48, 5 February 2016 | Pq2015-3.png (file) |  |
164 KB | |
| 01:48, 5 February 2016 | Pq2015-2.png (file) |  |
198 KB | |
| 01:48, 5 February 2016 | Pq2015-1.png (file) |  |
261 KB | |
| 01:31, 5 February 2016 | Colony5.JPG (file) |  |
353 KB | |
| 01:31, 5 February 2016 | Colony4.JPG (file) |  |
344 KB | |
| 01:31, 5 February 2016 | Colony3.JPG (file) | |
352 KB | |
| 01:29, 5 February 2016 | Colony2.JPG (file) |  |
324 KB | |
| 01:29, 5 February 2016 | Gram 10-7.JPG (file) |  |
1.3 MB | |
| 01:29, 5 February 2016 | Gram 10-5t.JPG (file) |  |
1.26 MB | |
| 01:29, 5 February 2016 | Gram 10-5.JPG (file) |  |
1.53 MB | |
| 01:29, 5 February 2016 | Colony1.JPG (file) | |
324 KB | |
| 01:27, 5 February 2016 | Gram 10-3t.JPG (file) |  |
1.24 MB | |
| 01:27, 5 February 2016 | 10-7.JPG (file) |  |
1.26 MB | |
| 01:27, 5 February 2016 | 10-5T.JPG (file) |  |
1.28 MB | |
| 01:27, 5 February 2016 | 10-5.JPG (file) |  |
1.27 MB | |
| 01:27, 5 February 2016 | 10-3T.JPG (file) |  |
1.62 MB | |
| 20:56, 29 January 2016 | Lab 2-3.jpg (file) |  |
16 KB | |
| 20:55, 29 January 2016 | Lab 2-2.jpg (file) |  |
101 KB | |
| 20:54, 29 January 2016 | Lab 2-1.jpg (file) |  |
464 KB | |
| 15:57, 15 January 2016 | TransectDrawing.jpg (file) |  |
1.64 MB |